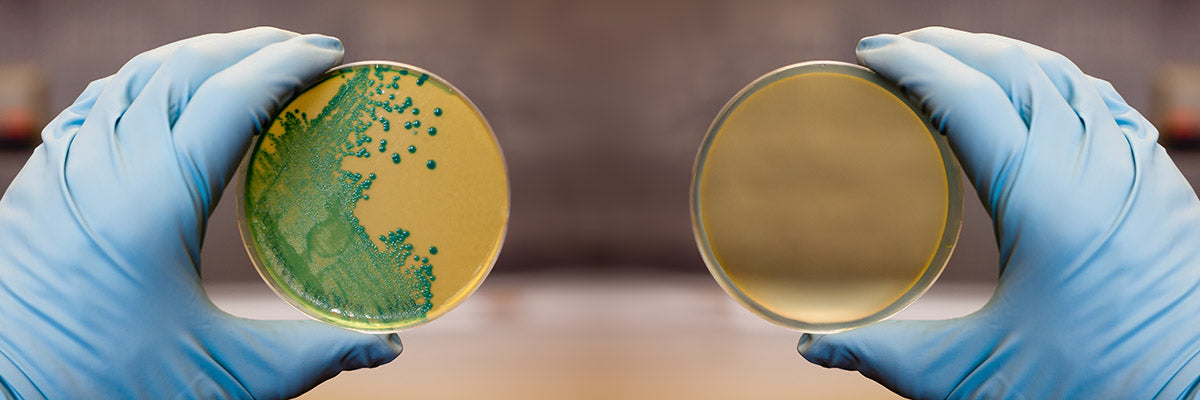
Petri dishes with Listeria before and after Spectral Blue blue light disinfection

Spectral Blue
SALO
SALO
Blue light disinfection device for biosafety cabinets & laminar hoods.
Features
Features
- MWHI blue light disinfection
- Plug & play
- Single-mode
Tests & Certifications
Tests & Certifications
- CE
- RoHS
- Blue Light Hazard





Product description and specifications
The SALO blue light disinfection device is a direct replacement for dangerous and ozone-generating UVC radiation devices in biosafety cabinets and laminar hoods. It is held in place with two strong magnets*. You can plug it into any 230 volt outlet, either inside the cabinet or outside it. The SALO XL is a longer variant, meant for larger cabinets.
The device is equipped with a 1-meter cord. Meant to be used with 230 VAC outlets with protective earth. Magnetic SALO BASE metal plates for installation in non-magnetic cabinets available as accessories.
Also download our Plug & Play devices brochure here (pdf).
| Name: | SALO |
SALO XL |
| Ordering code: | 23911 | 24071 |
| Features | MWHI blue light disinfection | |
| Power consumption: | 55 W | 105 W |
| Weight: | 2,2 kg | 4 kg |
| Dimensions: | L604 x H66 x W109 mm | L1160 x H66 x W109 mm |
| Average lifetime: | 50 000 h | |
| Operating temperature: | 0 - +40°C | |
| Beam angle: | 180° | |
| Protection class: | IP40 with power cord in place. IP30 without power cord. |
|
| Materials: | Aluminium + Steel + Glass | |
| Installation: | Magnets |
|
| Control method: | on/off | |
| Warranty: | 1 year. Extended warranty available. | |
| Certifications: | CE | |
| BLH risk group according to IEC 62471: | RG2 (moderate risk) < 494 mm, RG1 (low risk) ≥ 494 mm | |
Product information and specifications are subject to change.

Patented Multi-Wavelength, High-Intensity (MWHI) Technology
- Utilizes 405 nm + 450 nm visible blue light
- 5-10 x more powerful than single-wavelength applications
- Effective against the widest range of microbes

Continuous Disinfection
- Use Spectral Blue whenever the room is unoccupied for the maximum effect
- Even short bursts during the day can suppress microbial growth
- In continuous use, Spectral Blue pushes the room's bioburden down and then keeps it down
Works Against Biofilms, Multi-resistant Strains And Spore-formers
- Works against bacteria, yeasts and molds - also through biofilms
- Does not promote the development of antimicrobial resistance
Request Free 3D Disinfection Planning
The easiest way to get started - we can create a 3D model of your site or room and optimize the type and number of Spectral Blue MWHI® devices for your specific needs.






